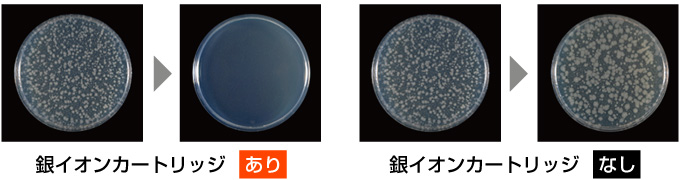

今お使いのビルトイン食洗機を交換するなら、今よりもさらに便利で快適に使いたいですよね。そこで、最新ビルトイン食洗機ってどうなの?と迷われている方へ、魅力的な機能別にご紹介しますので、ぜひ交換のご検討に参考にしてみてください!
便利な機能搭載のビルトイン食洗機を選ぼう!
1. カビ撃退でずっとキレイ!
「プラズマクラスター」による作用抑制メカニズム(イメージ図)

イオンの力で浮遊カビ菌※1や付着したニオイを抑制する注目の技術「プラズマクラスター」を食器洗い乾燥機に搭載しました。
※プラズマクラスターロゴおよびプラズマクラスター、Plasmaclusterはシャープ株式会社の登録商標です。
洗浄直後のクリーンな状態をキープ
食器の乾燥時に外気から取り込まれる空気をプラズマクラスターイオンが浄化。高濃度なプラズマクラスターイオンにより、浮遊カビ菌の分解・除去に加え、付着しているカビ菌の増殖も抑制します。また手洗いした食器も「クリーンキープコース」で保管すれば清潔さを保ちます。
付着カビ菌の増殖抑制効果

銀イオンの除菌効果で清潔長続きの「銀イオンカートリッジ」

銀イオンカートリッジの除菌効果
洗浄・すすぎの行程で銀イオンが溶け出し、抗菌作用の水が庫内に拡散し、食器や水槽全体に抗菌コート生成。銀イオンが細菌に浸入し、酵素の働きを停止させて繁殖を抑制します。水槽内に残った水も銀イオンの力で除菌効果を発揮!
自然にやさしく汚れを分解する「重曹コース」
自然素材「重曹」で汚れを中和し、自然成分に分解。専用洗剤を使わなくても汚れをしっかり洗い落とします。排水も、環境に無害な成分に分解する、人にも自然にもやさしい洗い方です。



















![住宅設備専門店[住設ドットコム]](/templates/img/pc/header_logo_pc.gif)
































